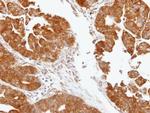
TDP1 Antibody in Immunohistochemistry (Paraffin) (IHC (P))

Search
Invitrogen
TDP1 Polyclonal Antibody
{{$productOrderCtrl.translations['antibody.pdp.commerceCard.promotion.promotions']}}
{{$productOrderCtrl.translations['antibody.pdp.commerceCard.promotion.viewpromo']}}
{{$productOrderCtrl.translations['antibody.pdp.commerceCard.promotion.promocode']}}: {{promo.promoCode}} {{promo.promoTitle}} {{promo.promoDescription}}. {{$productOrderCtrl.translations['antibody.pdp.commerceCard.promotion.learnmore']}}
产品信息
PA5-27111
种属反应
宿主/亚型
分类
类型
抗原
偶联物
形式
浓度
规格
纯化类型
保存液
内含物
保存条件
运输条件
RRID
产品详细信息
Recommended positive controls: 293T, A431, HeLa, HepG2.
Predicted reactivity: Rhesus Monkey (93%), Chimpanzee (97%).
Store product as a concentrated solution. Centrifuge briefly prior to opening the vial.
靶标信息
The protein encoded by this gene is involved in repairing stalled topoisomerase I-DNA complexes by catalyzing the hydrolysis of the phosphodiester bond between the tyrosine residue of topoisomerase I and the 3-prime phosphate of DNA. This protein may also remove glycolate from single-stranded DNA containing 3-prime phosphoglycolate, suggesting a role in repair of free-radical mediated DNA double-strand breaks. This gene is a member of the phospholipase D family and contains two PLD phosphodiesterase domains. Mutations in this gene are associated with the disease spinocerebellar ataxia with axonal neuropathy (SCAN1). While several transcript variants may exist for this gene, the full-length natures of only two have been described to date. These two represent the major variants of this gene and encode the same isoform.
⚠WARNING: This product can expose you to chemicals including mercury, which is known to the State of California to cause birth defects or other reproductive harm. For more information go to www.P65Warnings.ca.gov.
仅用于科研。不用于诊断过程。未经明确授权不得转售。
篇参考文献 (0)
生物信息学
蛋白别名: Tyr-DNA phosphodiesterase 1; Tyrosyl-DNA phosphodiesterase 1; unnamed protein product
基因别名: TDP1
UniProt ID: (Human) Q9NUW8
Entrez Gene ID: (Human) 55775